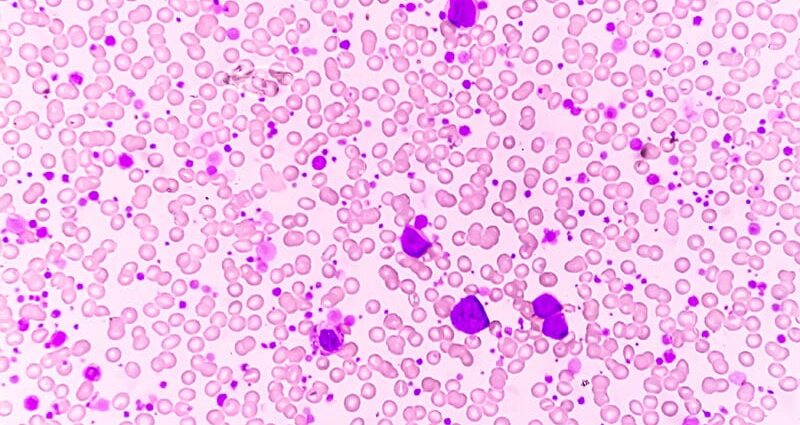
Ph-Positive Leukemia: No Longer a Death Sentence?

TOPLINE:
A combination of targeted treatment and immunotherapy has revolutionized Philadelphia chromosome–positive acute lymphoblastic leukemia management, achieving long-term survival rates of 75%-80% without systemic chemotherapy or transplantation.
METHODOLOGY:
- Researchers initiated a treatment protocol in 2000 using tyrosine kinase inhibitors plus glucocorticoids for induction without systemic chemotherapy.
- Analysis included first-, second-, and third-generation tyrosine kinase inhibitors evaluated over multiple years.
- Investigators enrolled adults aged ≥ 18 years with no upper age limit, who received dasatinib induction therapy for 84 days combined with glucocorticoids for the first 32 days.
- Results showed hematologic complete responses in 94%-100% of adults across all age groups, with limited toxic effects.
TAKEAWAY:
- All patients achieved complete hematologic remission with overall survival at 20 months of 69.2% and disease-free survival of 51.1%.
- A protocol involving patients older than 60 years who were not candidates for chemotherapy and transplantation demonstrated 94% complete hematologic remission at 6 weeks, with 2-year overall survival of 64%.
- After two cycles of blinatumomab, the percentage of patients with molecular response increased to 60% and continued to improve with additional cycles.
- At 18 months median follow-up, overall survival reached 95% and disease-free survival was 88%.
IN PRACTICE:
“This progress is an illuminating example of how a better understanding of the biology of a disease, the implementation of targeted treatment directed toward the underlying genetic defect, accurate molecular monitoring of the depth of response to treatment, and most recently, the addition of immunotherapy has provided a cure in most affected patients,” the authors of the study wrote.
SOURCE:
This study was led by Robin Foa, MD, Department of Translational and Precision Medicine, Sapienza University in Rome, Italy. It was published online in May in The New England Journal of Medicine.
LIMITATIONS:
During treatment, cardiac adverse events occurred in 29.5% of patients and vascular adverse events in 27.3% of patients. The high frequency of dose reductions (43.2%), treatment interruptions (43.2%), and treatment discontinuation (27.3%) suggests that a reduced initial dose should be considered.
DISCLOSURES:
Foa reported no disclosures.
This article was created using several editorial tools, including AI, as part of the process. Human editors reviewed this content before publication.